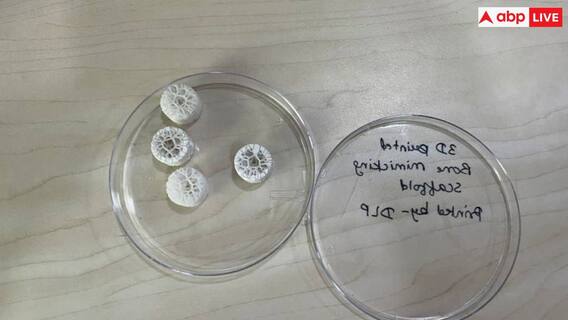

भारतीय प्रौद्योगिकी संस्थान (आईआईटी) कानपुर के एक प्रोफेसर ने दो केमिकल पेस्ट को मिलाकर टूटी हुई हड्डियों में इंजेक्ट करके हड्डियों को जोड़ने की नई तकनीक विकसित की है. यह तकनीक बनाने वाले बायोसाइंसेज और बायोइंजीनियरिंग विभाग के प्रोफेसर अशोक कुमार ने कहा, इससे सिंथेटिक हड्डी नैचुरल हड्डी जैसी बन जाएगी. भारत के दृष्टिकोण से इसे मेडिकल साइंस में क्रांति कहा जा सकता है. आईआईटी कानपुर के प्रोफेसर अशोक कुमार कहते हैं कि जिन लोगों की हड्डियां खतरनाक एक्सीडेंट में टूट जाती है उस दौरान यह सिंथेटिक बोन के जरिए आसानी से जोड़ दी जाएगी.
किस तरह से काम करेगा सिंथेटिक बोन
बुधवार को इस तकनीक को एक निजी कंपनी को दिया गया है. इसके कॉन्ट्रैक्ट पर हस्ताक्षर किए गए. प्रोफेसर अशोक ने बताया कि प्रभावित क्षेत्र में पहुंचने के 15 मिनट बाद माइक्रो पोरस जेल बहुत सख्त हो जाएगा. उन्होंने बताया कि इस मिश्रण से शरीर में ऑक्सीजन की आपूर्ति और रक्त संचार पर कोई असर नहीं पड़ेगा. जो ऊतक निर्माण और शरीर की खुद को ठीक करने की क्षमता के लिए बहुत महत्वपूर्ण है.
यह भी पढ़ें: Male Menopause: क्या मर्दों को भी होती है महिलाओं के मेनोपॉज जैसी दिक्कत? ढलती उम्र के साथ शरीर पर ऐसे पड़ता है असर
टीबी कैंसर और हड्डी में होती है बीमारी
प्रोफेसर ने बताया आमतौर पर हड्डी की टीबी या कैंसर के मामले में डॉक्टरों के पास प्रभावित अंग को काटने के अलावा कोई विकल्प नहीं होता है. क्योंकि हड्डी के दोबारा उगने की कोई उम्मीद नहीं होती है. वहीं, दुर्घटना में हड्डी टूटने की स्थिति में भी डॉक्टर आखिरी विकल्प के तौर पर उस अंग को काट देते हैं. इसके अलावा जांघ या शरीर के किसी अन्य हिस्से से हड्डी का टुकड़ा निकालकर प्रत्यारोपण किया जाता है. लेकिन इसमें भी संक्रमण या बीमारी की संभावना बनी रहती है.
Disclaimer: खबर में दी गई कुछ जानकारी मीडिया रिपोर्ट्स पर आधारित है. आप किसी भी सुझाव को अमल में लाने से पहले संबंधित विशेषज्ञ से सलाह जरूर लें.
यह भी पढ़ें: अंजीर खाना सेहत के लिए है फायदेमंद, जानें सही समय और एक दिन में कितना खाना चाहिए?